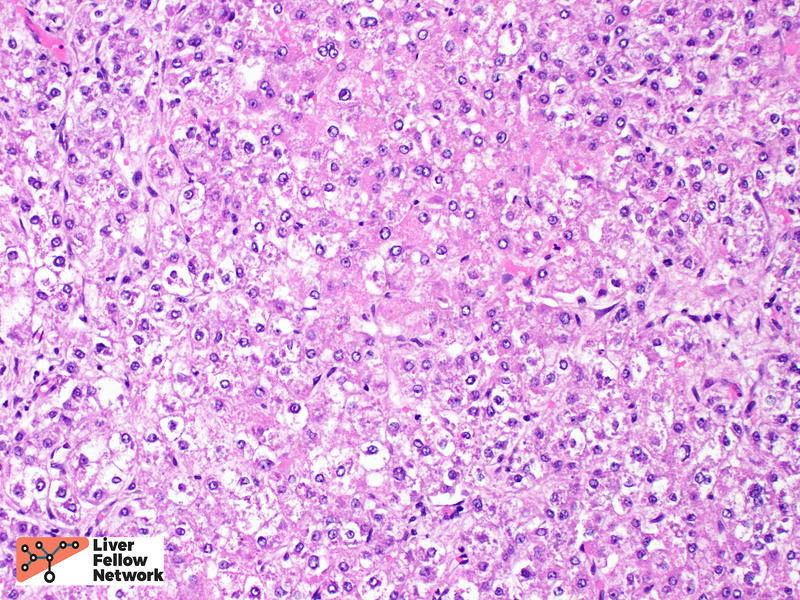

Pathology Pearls: Hepatocellular Carcinoma
Brief Case Presentation
A 60-year-old patient with a history of heavy drinking and liver compensated cirrhosis of liver (biopsy confirmed) presented for follow-up of cirrhosis. Lab tests were obtained (below). Computed tomography abdomen demonstrated a 4.0 cm mass.
Lab TestResult
- AST: 33 U/L (0 - 39 U/L)
- ALT: 23 U/L (0 - 52 U/L)
- Alk. Phos: 49 U/L (34 - 104) U/L
- Total Bilirubin: 0.4 g/dL (0.0 - 1.0 g/dL)
- CEA: 6.9 ng/mL (>3.0 ng/mL)
- AFP: 15.3 ng/mL (0.0 - 13.0 ng/mL)
- CA-125: 11 U/mL (<21 U/mL)
Interventional radiology performed a targeted biopsy of the liver lesion.
General Approach to the Liver Biopsy of a Mass Lesion
Before we discuss the biopsy findings, let us review the general approach of the pathologist when diagnosing a liver mass on biopsy.
Question 1: The biopsy is labelled “Liver Mass.” Does the tissue represent a liver mass or not?
For background reading on this topic, please review previous Pathology Pearls Posts 1. Normal Liver Histology 101, 2. The Liver Biopsy: Importance and Interpretation, and 3. Liver Biopsy Interpretation: Special Stains.
Most often, the biopsy tissue will be representative of the liver mass seen on radiology. However, there are some reasons why the biopsy tissue may not correlate to a liver mass. Sometimes, the liver biopsy labelled “Liver Mass” only contains cirrhotic liver with regenerative nodules. In other instances, the biopsy may represent sampling adjacent to the mass, rather than the mass itself. Knowledge of normal liver architecture, and use of special stains, especially reticulin, will help answer Question #1.

Question 2: The tissue does represent the mass. Is it benign or malignant?
This is the biggest question facing the pathologist and arriving at the correct answer is paramount to guiding patient management. Two of the common benign mass forming liver lesions are focal nodular hyperplasia (FNH) and hepatic adenoma. On biopsy, both can be challenging to distinguish from well-differentiated hepatocellular carcinoma. Careful attention to liver architecture (presence of portal tracts, thickness of hepatic plates, clues from the background liver) will point toward the diagnosis, and special stains (particularly reticulin) will be helpful to highlight the reticulin framework. The diagnosis of FNH can be aided by an immunohistochemical stain for glutamine synthetase, which is usually only positive in the centrizonal hepatocytes, but in FNH will show an expanded, “map-like” pattern of staining. Imaging prior to biopsy will also provide helpful evidence supportive of FNH.

Question 3: The lesion is malignant. Is it primary liver in origin (such as hepatocellular carcinoma or cholangiocarcinoma) or is it a metastasis?
This is another big question facing the pathologist. Determining the correct answer to this question will drive the correct management. In well-differentiated lesions, this is not usually a difficult question to answer, because the tumor cells resemble hepatocytes, or show evidence of hepatocellular differention (such as bile production), or will express hepatocellular lineage markers by immunohistochemistry, such as HepPar1 or Arginase. However, the more poorly differentiated a tumor becomes, the harder this question is to answer. Careful examination of the tumor morphology, and judicious use of lineage-specific protein markers via immunohistochemistry will aid in answering Question 3.

Question 4 (usually answered at resection): If the lesion is hepatocellular carcinoma; What type of hepatocellular carcinoma is it? What prognostic features are necessary to report to guide patient management?

Once the diagnosis of hepatocellular carcinoma is achieved, the pathologist’s work is not over. When looking at the eventual resection specimen, the pathologist must be able to provide accurate information about the tumor’s grade and stage, the response to therapy (if treated), and provide any other relevant prognostic information. The details of this question will be reviewed as we proceed through this case. Let’s begin by looking at the biopsy core.
Liver Biopsy
Low power view of the core biopsy showed a solid area of pink/eosinophilic polygonal cells forming a compact nest. Adjacent to the solid area, there was fibrosis and chronic inflammatory cells, suggestive of background cirrhosis. (Figure 1).
Within the solid area, no portal tracts were identified. (Figure 2, top). At highest magnification, the tumor cells show round, slightly enlarged nuclei, and occasional prominent nucleoli. (Figure 2, bottom).
A reticulin stain showed loss of the supporting reticulin framework. A Ki-67/MIB-1 immunohistochemical stain highlighted many proliferating cells. (Figure 3).
These biopsy findings are consistent with a well-differentiated hepatocellular carcinoma.
Hepatocellular carcinoma
The epidemiology of hepatocellular carcinoma (HCC) has shifted over the past decades. Overall, incidence is increasing, and is becoming prevalent in Europe and United States. Worldwide, chronic hepatitis B infection is still the largest contributor in HCC incidence, whereas in developed countries the underlying etiologies have shifted away from hepatitis C infection and toward nonalcoholic fatty liver disease and alcoholic liver disease[1]. See this great Liver Fellows Network post for a review on the epidemiology and risk factors associated with hepatocellular carcinoma.
HCC is detected frequently detected radiographically[2], and the typical findings of arterial enhancement, size, venous phase washout, presence of capsule, and growth are combined into a 5-point score (Liver Imaging Reporting and Data System, LI-RADS). Biopsy is not needed to initiate treatment. However, biopsy is still performed in cases of atypical findings.
Upon resection, HCC usually has a mass forming appearance distinct from the background liver, often has a brown to green cut surface secondary to bile production (Figure 4), and may have satellite nodules separate from the primary mass.

Histologically, HCC is typified by a mass-forming tumor with cells that resemble hepatocytes (in cases of well-differentiated HCC). A reticulin stain is often of great value in establishing the diagnosis of HCC. While loss and/or fragmentation of the reticulin framework can often clinch the diagnosis (as in the biopsy described above); many cases of well-differentiated HCC do not lose reticulin entirely. Nevertheless, reticulin is still valuable to aid in identification of subtle widening of the hepatic plates, needed for the diagnosis (see example in Figure 5).
Tumor cell morphology can be helpful, as one can frequently find areas of cytologic atypia (Figure 6, top). Other evidence of hepatocellular differentiation include bile production (Figure 6, bottom).
The most common architectural patterns are solid, trabecular (in which tumor cells grow in thickened hepatic plates separated by sinusoidal spaces), and acinar/pseudoglandular patterns (in which the tumor cells form small nests with central degeneration that resembles glands), Figure 7. However, the poorly differentiated HCCs will often grow as solid masses and will not resemble normal hepatocytes (Figure 8).
HCC is often treated by ablation or radioablation prior to surgical resection (Figure 9). In such cases, the role of the pathologist is not only to confirm the diagnosis, but to report on response to therapy and provide additional prognostic information (such as presence of lymphovascular invasion, Figure 10).
The histologic subtype of HCC is another prognostic factor. Some subtypes have a similar or even better prognosis compared to “conventional” HCC, whereas others have a distinctly worse prognosis. An abbreviated table of histologic subtypes[3] (Table 1), and select illustrations are provided below (Figures 11 and 12).
Subtype (Frequency %): Prognosis (vs Conventional HCC)
- Steatohepatitic (20%): Similar
- Clear cell (7%): Better
- Scirrhous (4%): Similar or Better
- Combined hepatocellular-cholangiocarcinoma (1%): Worse
- Macrotrabecular (1%): Worse
- Fibrolamellar (1%): Better
- Sarcomatoid (<1%): Worse
Differential Diagnosis
The differential diagnosis for hepatocellular carcinoma can be broad, depending on the clinical context (age and sex of the patient), composition of the background liver, and presence or absence of possible metastatic disease. Hepatic adenoma is an important differential consideration, most often in young or middle-aged females. Hepatic adenoma should only show hepatic plates of 1-2 cells thickness and should not demonstrate any significant cytologic atypia. Focal nodular hyperplasia is a benign, tumor-like lesion that is thought to be a proliferative/hyperplastic response to localized abnormal blood flow. In addition to showing normal hepatic plate thickness in the lesion which is surrounded by fibrous septa that may form a central scar, focal nodular hyperplasia shows a characteristic “map-like” staining pattern when stained for glutamine synthetase by immunohistochemistry. Regenerative nodules, often seen in cirrhosis can mimic a mass lesion; however, portal tracts should be identified within the nodule. Primary intra-hepatic cholangiocarcinoma is another primary malignancy that may be considered. Cholangiocarcinoma (a topic of a future LFN post), should show malignant gland formation, usually has evidence of mucin production, and frequently causes a markedly fibrotic and inflammatory response from the normal liver around it, also known as a desmoplastic stromal response. Separating HCC from metastatic tumors will rely on knowledge of the patient’s previous clinical history, if known, and use of lineage-specific protein markers via immunohistochemistry to identify the site of origin.
References
- Caines, A., Selim, R., and Salia, R. The changing global epidemiology of hepatocellular carcinoma. Clinics in Liver Disease. 2020; 24 (4): 535-547.
- Reynolds AR, Furlan A, Fetzer DT et-al. Infiltrative hepatocellular carcinoma: what radiologists need to know. Radiographics. 2015;35 (2): 371-86.
- Otranto, M. et al. The role of the myofibroblast in tumor stroma remodeling. Cell Adhes Migr 6, 203–219 (2012).
- Torbenson, M.S. Morphologic Subtypes of Hepatocellular Carcinoma. Gastroenterology Clinics of North America. 2017; 46 (2): 365-391.